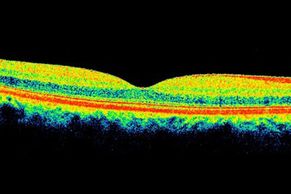

En Ophthalmo Médica tratamos todas las afecciones de los ojos para las cuales existen tratamientos aprobados por la evidencia científica. Hemos reunido en un solo lugar a los especialistas y equipos médicos y tecnológicos para darte la atención que tus ojos merecen. Estas son algunos de los tratamientos que ofrecemos.

Una catarata es una opacidad de la transparencia normal del cristalino del ojo. En el caso de las personas que tienen cataratas, ver a través de cristalinos opacos es un poco como mirar a través de una ventana empañada o escarchada. En Ophthalmo Médica ofrecemos la mas avanzada tecnología para corregir la catarata con lentes intraoculares monofocales o multifocales.

Complicación de la diabetes que afecta los ojos.
La retinopatía diabética aparece como resultado del daño en los vasos sanguíneos del tejido ubicado en la parte posterior del ojo (retina). El azúcar en la sangre no controlado correctamente es un factor de riesgo.
En Ophthalmo Médica contamos con los retinólogos y equipos médicos para el tratamiento integral de esta patología.

El LASIK es un tipo de cirugía refractiva. Este tipo de cirugía utiliza un láser para tratar los problemas de visión causados por errores refractivos (miopía, hipermetropía, astigmatismo). Una persona tiene un error refractivo cuando el ojo no refracta (dobla) la luz adecuadamente. Si ya estas cansado de usar las gafas, te ofrecemos esta solución para tu error refractivo.

La fotocoagulación retiniana es un procedimiento terapéutico que realizamos en Ophthalmo Médica. Consiste en la aplicación de un haz láser sobre la estructura más profunda del ojo, la retina

El glaucoma es una enfermedad que daña el nervio óptico del ojo. Generalmente se produce cuando se acumula fluido en la parte delantera del ojo. El exceso de fluido aumenta la presión en el ojo y daña el nervio óptico.

La degeneración macular relacionada con la edad es una enfermedad asociada con el envejecimiento que gradualmente destruye la visión central y el detalle de la imágenes. La visión central hace falta para ver con claridad y para realizar tareas diarias como por ejemplo leer y conducir.

En Ophthalmo Médica tenemos al servicio de tus ojos este innovador equipo que en pocos segundos mide y analiza 6 parámetros oculares de importancia para tu médico. El estado refractivo, la presión intraocular, el poder keratométrico, el grosor de tu córnea, la capacidad de enfoque del lente interno del ojo y la opacidad del mismo.

La tomografía de coherencia óptica (OCT) es un estudio de imágenes no invasivo que utiliza ondas de luz para obtener imágenes en corte transversal de la retina.
La misma deja ver cada una de las diferentes capas que forman la retina. Esto nos permite hacer un diagrama y medir su grosor. Estas medidas nos ayudan a determinar tu diagnóstico.

El OPD-Scan III es un autorefractor, keratómetro, pupilometro (hasta 9.5mm), topógrafo corneal y aberrometro de frente de onda. El OPD-Scan III completa 20 mediciones diagnósticas en menos de 10 segundos por ojo. (including angle kappa, HOAs, average pupil power, RMS value, and point spread function). Easy alignment and automatic capture of wavefront aberrometry data ensures accurate readings. Wavefront aberrometry data is gathered from available zones up to a 9.5mm area, adding the capability to provide for calculation of mesopic refractions. Blue light, 33 ring, placido disc topography is gathered in one second. Mapping methods include OPD, visual acuity corneal topography/topographer, and more.

Su campo visual es la amplitud del área que su ojo puede ver cuando enfoca en un punto central. La prueba de campo visual es una forma en la que medimos qué tanta visión tiene en cada ojo, y cuánta pérdida de visión ha podido tener a través del tiempo.

La biometría realizada con interferometría o por ultrasonido modo A (lineal) es una técnica no invasiva, rápida y no dolorosa que permite realizar mediciones de las estructuras oculares. Los factores más importantes para obtener un cálculo correcto del poder dióptrico de una lente intraocular son la longitud axial y la queratometría.

La topografía corneal es una técnica diagnóstica que permite analizar completamente la córnea. De esta forma es posible detectar alteraciones corneales, así como ajustar las lentes de contacto específicas. Además, se trata de una técnica esencial para las cirugías refractivas.

En Ophthalmo Médica tenemos al servicio de tus ojos este innovador equipo que en pocos segundos mide y analiza 6 parámetros oculares de importancia para tu médico. El estado refractivo, la presión intraocular, el poder keratométrico, el grosor de tu córnea, la capacidad de enfoque del lente interno del ojo y la opacidad del mismo.
La tomografía de coherencia óptica (OCT) es un estudio de imágenes no invasivo que utiliza ondas de luz para obtener imágenes en corte transversal de la retina.
La misma deja ver cada una de las diferentes capas que forman la retina. Esto nos permite hacer un diagrama y medir su grosor. Estas medidas nos ayudan a determinar tu diagnóstico.

Su campo visual es la amplitud del área que su ojo puede ver cuando enfoca en un punto central. La prueba de campo visual es una forma en la que medimos qué tanta visión tiene en cada ojo, y cuánta pérdida de visión ha podido tener a través del tiempo.

La biometría realizada con interferometría o por ultrasonido modo A (lineal) es una técnica no invasiva, rápida y no dolorosa que permite realizar mediciones de las estructuras oculares. Los factores más importantes para obtener un cálculo correcto del poder dióptrico de una lente intraocular son la longitud axial y la queratometría.

La topografía corneal es una técnica diagnóstica que permite analizar completamente la córnea. De esta forma es posible detectar alteraciones corneales, así como ajustar las lentes de contacto específicas. Además, se trata de una técnica esencial para las cirugías refractivas.

El Ultrasonido Ocular modo B es un método de estudio ultrasónico (ecográfico), no invasivo que permiten la medición y el estudio del ojo y sus anexos profundos. Es imprescindible cuando los medios ópticos son opacos y no se puede observar la retina y estructuras profundas con otros métodos.

Es un estudio de imagen no invasivo, en el que se toman fotografías digitales del segmento anterior del ojo.

Es un estudio de imagen no invasivo, en el que se toman fotografías digitales del polo posterior del ojo.